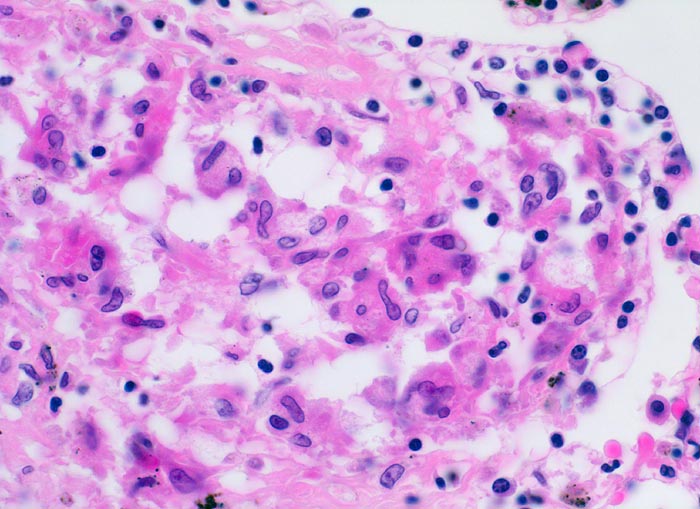

PathoPic – image database / PathoPic ID 4709 - Sarkoidosegranulom
de
Diagnose
Sarkoidosegranulom
Diagnose Gruppe
Systemerkrankung/Immunpathologie
Topographie
Lunge
Topographie Gruppe
Lunge, Mediastinum mit Thymus
Beschreibung
Zusatzbefund
In Spezialfärbungen lassen sich weder Pilze noch Bakterien nachweisen.
Klinik
bekannte Sarkoidose
Bilder Typ
Histologie
Vergrösserung
400
Alter
46
Geschlecht
unbekannt
Datum
Ersteintrag: 08.07.2002